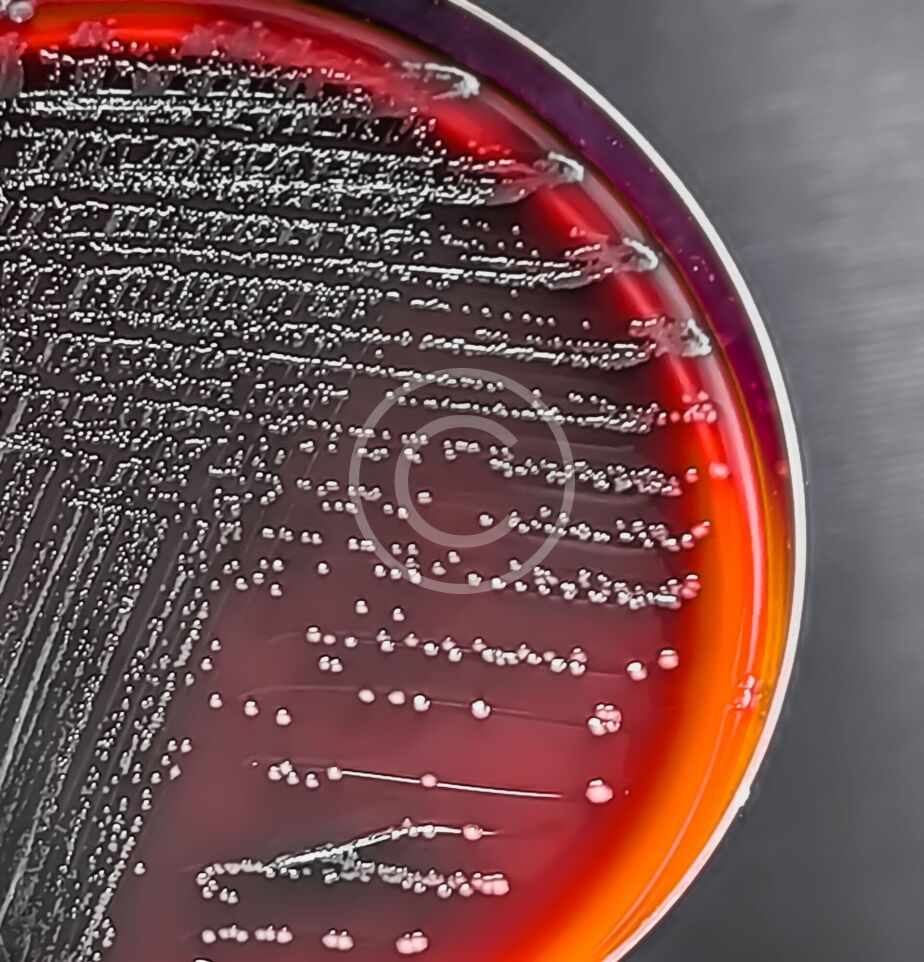

[ Wellbeing Champion ]
A Landmark Partnership
Government
to Empower the Wellbeing of Abu Dhabi
Employees.
Visual Cards
Explore the Pillars, Plans, and Initiatives
Gain a comprehensive overview of the “Wellbeing Champion” project through its seven core pillars, twelve wellness plans, and five practical initiatives designed to create real change in both workplace and life

About the Program
Discover the seven pillars that shape the “Wellbeing Champion” journey.


A Journey Towards Sustainable Health


About the Program
The "Wellbeing Champion" Journey: An Integrated Structure for Sustainable Impact
The “Wellbeing Champion” project is more than just a health program; it is a strategic investment in the human capital of the Abu Dhabi Government. Through our integrated approach, which combines precise scientific assessments, innovative personal plans, and continuous follow-up, we empower each participant to lead their health journey with confidence and awareness to achieve their full potential in work and life.
The program is structured to take each participant on an integrated and organized 20-week journey, starting from understanding their current state and ending with measuring tangible, positive impact. Each phase builds on the last to ensure maximum benefit and success
Phase 1
Baseline Assessments (4 weeks): We lay the foundation for your journey with precise health and biometric assessments to understand your unique needs.
Phase 2
12 Interactive Tactical Plans (4 weeks): We design 12 personalized, SMART-based wellness plans for you, with clear performance indicators to achieve your goals.
Phase 3
Implementation and Execution (8 weeks): We turn plans into reality through 5 practical and engaging initiatives focused on fitness, nutrition, and healthy sleep.
Phase 4
Bi-Weekly Progress Reports (20 weeks): We ensure transparency and follow-up through 50 periodic reports summarizing the progress made in each initiative.
A Landmark Partnership to Empower the Wellbeing of Abu Dhabi Government Employees
In collaboration with the Department of Government Enablement, Everlast Wellness Medical Center presents the "Wellbeing Champion" project, a transformative 20-week program designed to establish a culture of holistic wellbeing, driven by data-driven insights and tailored to the values and culture of Abu Dhabi.
Socials
Office locations

Have questions? Get in touch!
Need pharma support today?
Common questions answered
Pharma is committed to helping you access trusted lab and pharmacy solutions, with expert help at every step of the way.
How do I start with Pharma?
Contact us by email or phone to begin. Our team will organize a call to learn about your needs and tailor our help to you.
Can I book a remote consultation ?
Yes, we hold online meetings, connecting you with Pharma experts no matter where you are, for easy, fast support.
What sectors does Pharma cover?
We serve healthcare, labs, and research groups, providing services that match the unique needs of each client sector.
Do you support new ventures too?
We enjoy helping startups thrive! Our expert team guides new labs and firms as they launch and grow their projects.